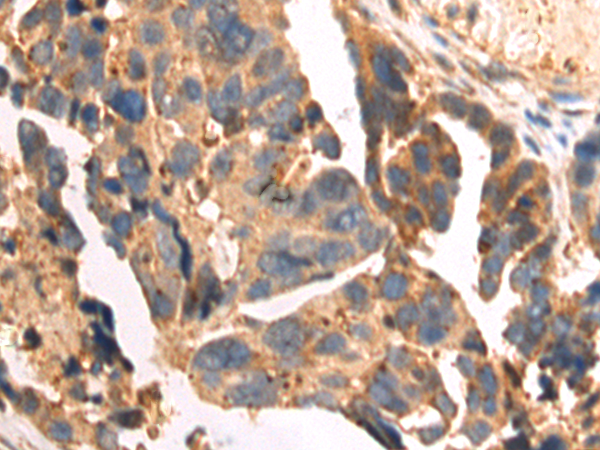
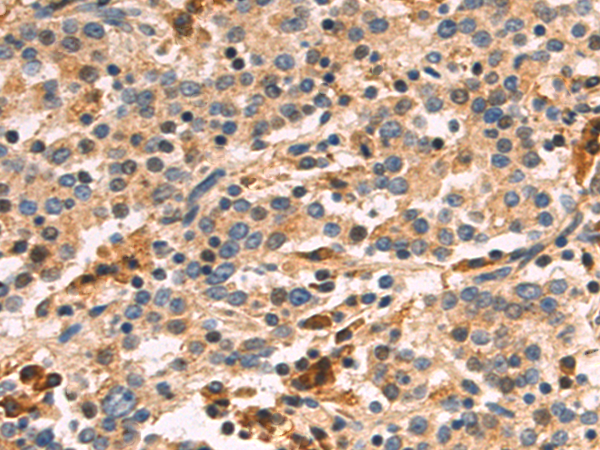
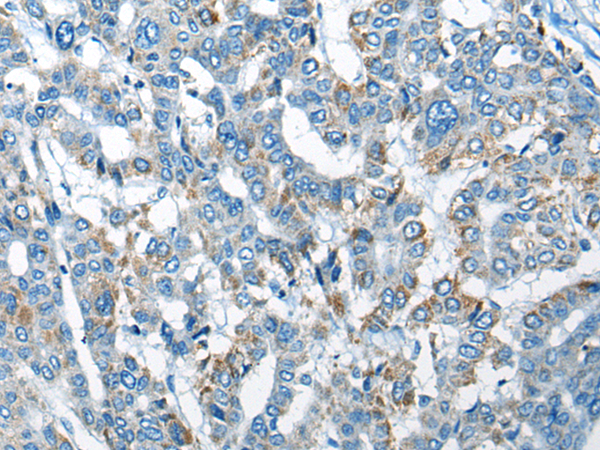
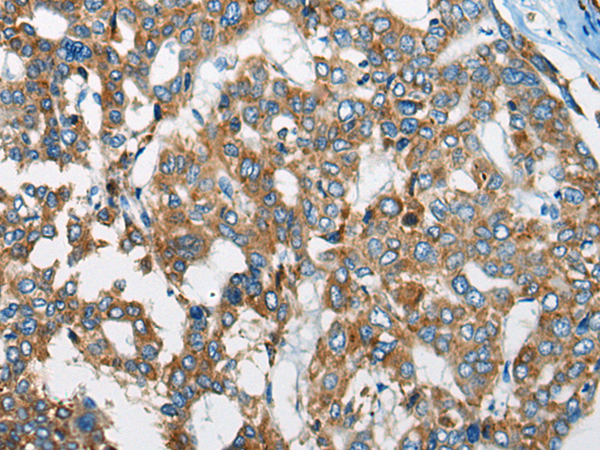
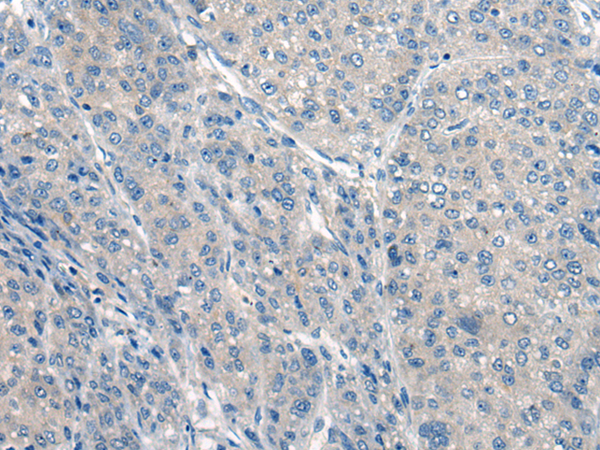
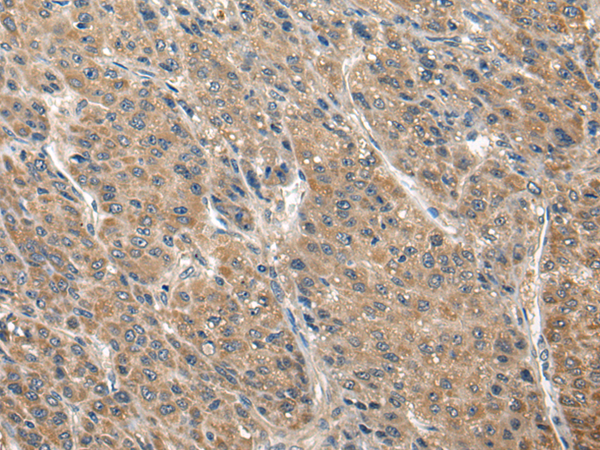

-
分类: 科研抗体货号: P13078别名: MT75; PRED12; C21orf68应用: IHC反应种属: Human, Mouse
-
分类: 科研抗体货号: P13077别名: TCD; GGTA; REP-1; DXS540; HSD-32应用: IHC反应种属: Human
-
分类: 科研抗体货号: P13074别名: SLRR4B应用: IHC反应种属: Human
-
分类: 科研抗体货号: P13095别名: NCL应用: WB,IHC反应种属: Human, Mouse
-
分类: 科研抗体货号: P13073别名: CGI-62; C8orf70; FAM164A应用: IHC反应种属: Human, Mouse
-
分类: 科研抗体货号: P13094别名: CLIC1L应用: IHC反应种属: Human, Mouse, Rat
-
分类: 科研抗体货号: P13072别名: ZA20D1; CEZANNE应用: IHC反应种属: Human, Mouse
-
分类: 科研抗体货号: P13093别名: CLCK1; ClC-K1; hClC-Ka应用: IHC反应种属: Human, Mouse
-
分类: 科研抗体货号: P13071别名: iCE; CE-2; PCE-2; CES2A1应用: WB,IHC反应种属: Human
-
分类: 科研抗体货号: P13092别名: CLTD; CHC22; CLH22; CLTCL应用: IHC反应种属: Human

鄂公网安备42018502007531号
鄂公网安备42018502007531号

